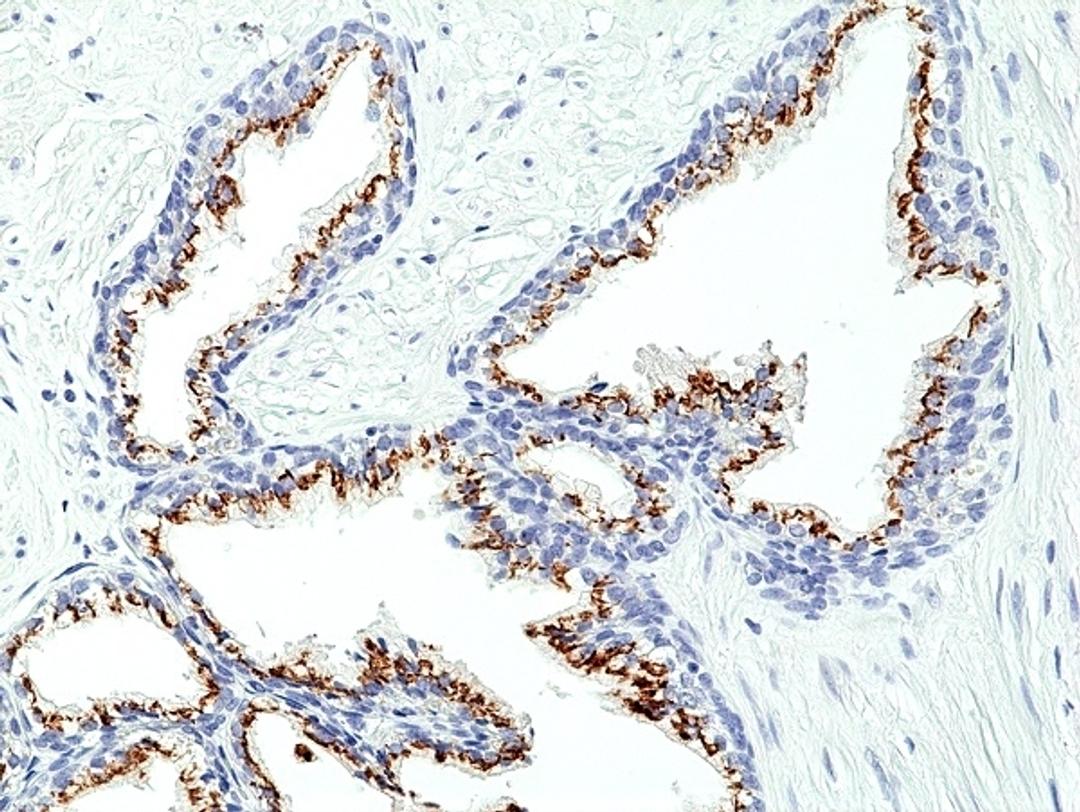

Product & ReviewsAntibodies
PROSTEIN
RABBIT ANTI PROSTEIN
Product Details
- Cat. No.
- MCA6366
- Type
- Primary Antibody
- Clonality
- Monoclonal
- Host
- Rabbit

The supplier does not provide quotations for this antibody through SelectScience. You can search for similar antibodies in our Antibody Directory.
Reviews
Applications
- Immunohistochemistry (Paraffin-Embedded Sections) (IHC (P))
Antibody Overview
About the company

Bio-Rad
Bio-Rad Laboratories, Inc. is a multinational manufacturer and distributor of life science research products, clinical diagnostics, and analytical instrumentation, based in Hercules, California. The company serves more than 70,000 research and industry customers worldwide through a network of more than 30 wholly owned subsidiary offices.